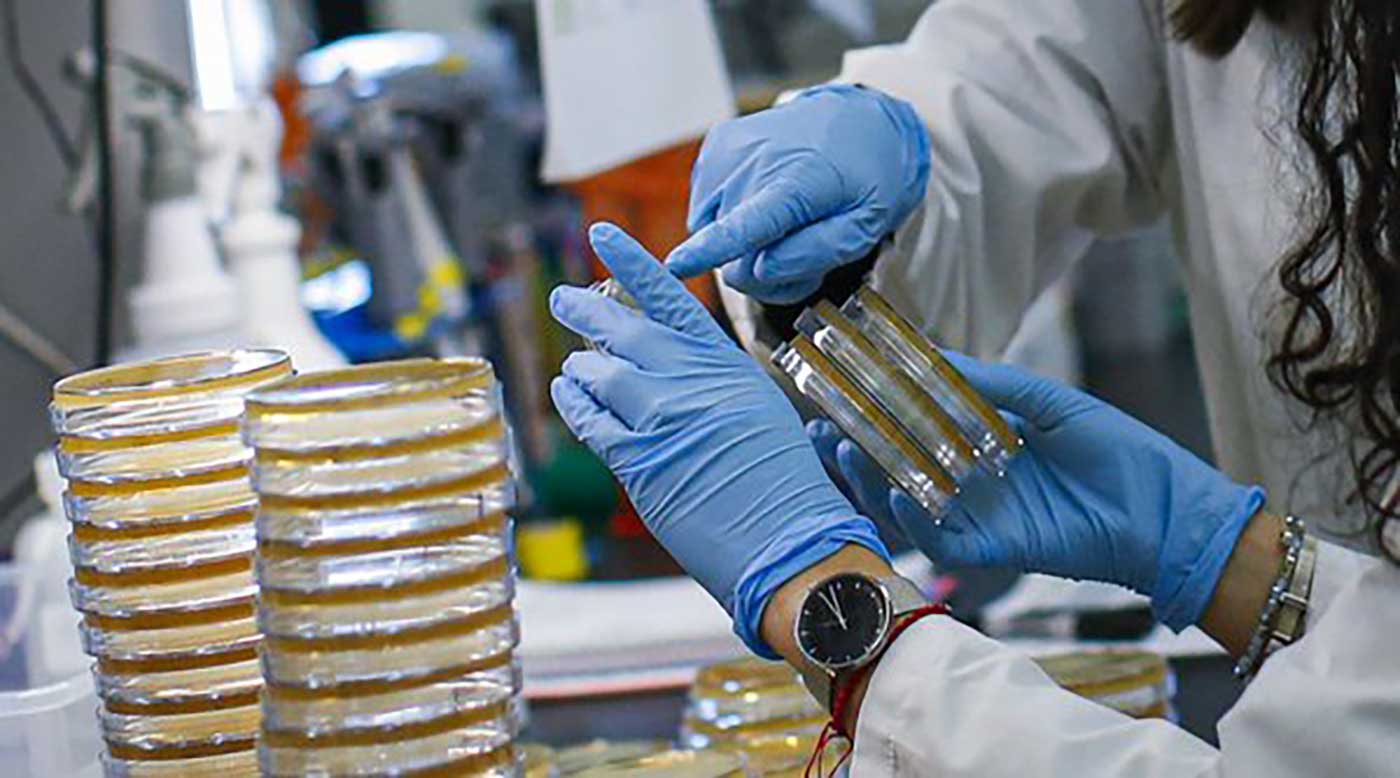

أعلنت لجنة الصحة الصينية، اليوم السبت، ارتفاع عدد الوفيات بفيروس كورونا في البلاد إلى 3189 بنهاية يوم أمس، بعد تسجيل 13 حالة وفاة.
وقالت اللجنة في بيان بثه التلفزيون الصيني الرسمي: "تم تسجيل 11 إصابة جديدة ليبلغ العدد الكلي للإصابات منذ تفشي الفيروس إلى 80824 إصابة".
ومساء أمس، أعلن المدير العام لمنظمة الصحة العالمية تيدروس أدهانوم جيبريسوس، أن أكثر من 5 آلاف شخص قضوا بفيروس كورونا حتى الآن، وأن أوروبا أصبحت "بؤرة" لهذا الوباء.
وقال جيبريسوس في المؤتمر اليومي للمنظمة: "تجربة الصين وكوريا الجنوبية أثبتت أن العزل الصحي يمكن أن ينقذ أرواح الكثير من الناس"، مؤكدا أنه "على المؤسسات الصحية في العالم أن تكون مستعدة لاستقبال أعداد كبيرة من المرضى".
وجدد جيبريسوس التأكيد على أهمية الإجراءات الوقائية التي أعلنتها المنظمة في السابق للوقاية من الإصابة بفيروس كورونا، والمتمثلة بغسل اليدين بالماء والصابون أو تعقيمهما بمادة تحوي على معقم كحولي، وتغطية الفم والأنف عند السعال والعطاس، والبقاء في المنزل في حال الشعور بالمرض، وتجنب السفر بدون ضرورة وكذلك التجمعات البشرية الكبيرة.